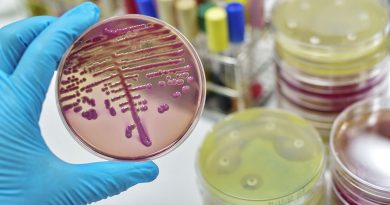

Alerta hoy por nieve en una provincia: las recomendaciones
El Servicio Meteorológico Nacional renovó para este lunes sus advertencias por fuertes nevadas.

Alerta hoy por nieve en una provincia: las recomendaciones
Inicia una nueva semana que se prevé con mal clima en algunas partes del país, por lo que el Servicio Meteorológico Nacional (SMN) renovó sus alertas por nieve y fuertes nevadas.
De esta manera, se mantenía este lunes un alerta amarilla fuertes nevadas para toda la zona sur de la cordillera de Neuquén.
Alerta amarilla por nieve
De acuerdo con el reporte del organismo, “el área será afectada por nevadas de variada intensidad. Se esperan valores de nieve acumulada entre 15 y 25 cm, pudiendo ser superados de manera puntual».
Los mayores acumulados se esperan en las zonas más altas; mientras que no se descarta la precipitación en forma de lluvia en las zonas mas bajas.
Recomendaciones del SMN por fuertes nevadas
Evitá actividades al aire libre.
Retirá periódicamente la nieve acumulada en los techos.
Circulá con vehículos adecuados y preparados para hielo y nieve.
Ventilá vehículos y viviendas para evitar acumulación de monóxido de carbono.
Informate por las autoridades. Tené siempre lista una mochila de emergencias con linterna, radio, documentos y teléfono.